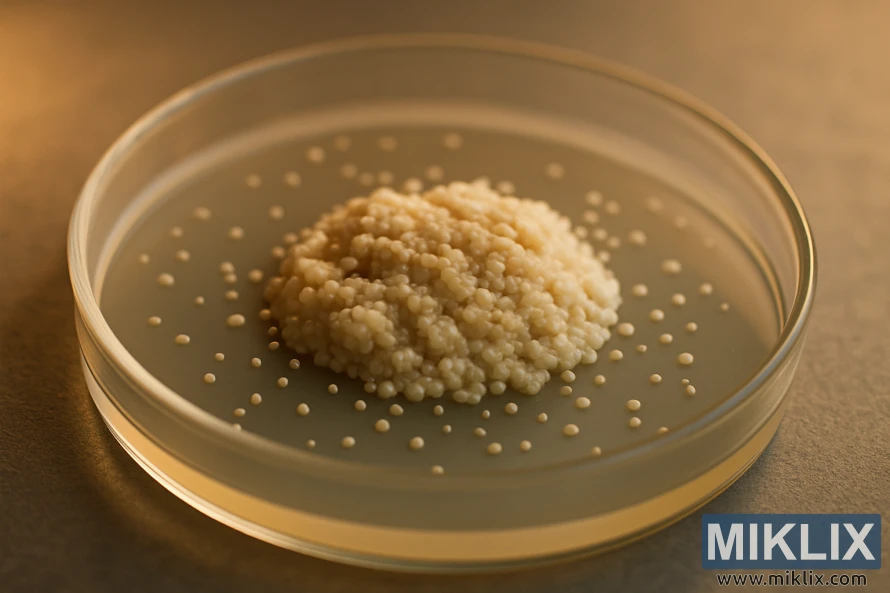
Nærbilde av en kremet ølgjærkultur i en petriskål under varmt lys.

Gjæring av øl med Lallemand LalBrew Diamond Lager-gjær
Publisert: 25. september 2025 kl. 18:09:12 UTC
Denne artikkelen går inn på detaljene til Lallemand LalBrew Diamond Lager Yeast for hjemmebryggere. Den tar sikte på å vurdere dens evne til å produsere sprø, ren lagerøl og dens pålitelighet under gjæring. Fokuset er på hvor godt Diamond oppfyller disse forventningene i typiske hjemmebryggingsoppsett.
Fermenting Beer with Lallemand LalBrew Diamond Lager Yeast

Tilbakemeldinger fra bryggere indikerer at Diamond utmerker seg i temperaturer rundt 10 °C. Det kan ta 24–48 timer før de første tegnene på gjæring viser seg. Når den er aktiv, fremkaller den de klassiske lageraromaene, inkludert en mild svovelaktig tone som avtar med tiden. Disse observasjonene gjenspeiles i en rekke anmeldelser av Diamond-lagerøl og på nettfora.
Praktiske hensyn inkluderer gjæringstemperaturen og antall pakker som trengs for en batch på over 20 liter. Mange bryggere velger to pakker. Temperaturkontroll er også viktig, med vanlige metoder som gjæring i en kjeller ved 14 °C eller bruk av en fryser med en kontroller for mer presis kontroll.
Denne innledningen skisserer artikkelens fokus, inkludert detaljerte råd om gjæring, starterkulturer og gjæringstemperaturer. Feilsøkingstips vil også bli gitt for å hjelpe deg med å oppnå best mulig resultat med Lallemand LalBrew Diamond Lager Yeast.
Viktige konklusjoner
- Lallemand LalBrew Diamond Lager-gjær er utviklet for rene og sprø lagerøl.
- Fungerer bra i 10 °C; den første aktiviteten kan være langsom i 24–48 timer.
- Vanlig praksis er to pakker for 5+ gallon partier med nøye pitchingtemperatur.
- Forvent milde svovelaktige aromaer under aktiv gjæring som avtar under kondisjonering.
- Kjellerfermentering eller en fryser med kontroller er vanlige oppsettsvalg.
Hvorfor velge Diamond Lager-gjær for sprø, ren lagerøl
LalBrew Diamond er det perfekte valget for bryggere som søker en ren lagergjær. Den utmerker seg i å produsere sprø, nøytrale øl. Egenskapene er ideelle for bleke lagerøl og kontinentale stiler, noe som resulterer i en klar, gyllen fargetone og en subtil aroma.
Brukerne synes Diamonds gjæring er konsistent, med minimal esterproduksjon når gjæringen og kondisjoneringen gjøres riktig. Denne nøytraliteten lar smakene av humle og malt komme frem, uten at gjæren overdøver dem med fruktige noter eller sterke fenoler.
Diamant er pålitelig ved typiske lagertemperaturer, noe som gjør den til et pålitelig valg for hjemmebryggere. Den er også en god erstatning for forurensede flytende kulturer, noe som sikrer god demping og klarhet.
- Ren gjæringsadferd som produserer et stabilt, nøytralt lerret.
- Diamond-lager-karakteristikker som passer til lette til middels fyldige lagerøl.
- Forutsigbar lagersmaksprofil verdsatt i klassiske kontinentale øl.
- Pålitelig gjæring for bryggere som søker konsistente resultater.
For de som sikter mot autentiske lagerøl, gjør LalBrew Diamond reisen enklere. Den minimerer usikkerheten rundt gjæringen, slik at bryggerne trygt kan tappe eller tønne sine rene, lyse kreasjoner.
Emballasje, tilgjengelighet og produktdetaljer
Lallemand markedsfører LalBrew Diamond som en kommersiell tørrgjær for hjemmebryggere og små bryggerier. Den kommer i forseglede pakker, noe som sikrer holdbarhet og forenkler lagring for de som planlegger flere omganger.
Forhandlernes nettsider gir detaljert informasjon om LalBrew Diamonds emballasje, celletall og tilbakemeldinger fra kunder. De hjelper bryggere med å sammenligne alternativer og bestemme riktig mengde for en fem-gallons lager. Mange velger to pakker til sin første lager for å garantere robust gjæring.
Tilgjengeligheten av gjær kan variere med sesong og forhandler. Lokale butikker og nettbutikker fører ofte Diamond lagergjær. Lister viser gjeldende lagernivåer. Forhandlere kan tilby fraktavtaler og fornøydhetsgarantier, noe som påvirker beslutningen om hvor man skal kjøpe.
Før brygging, sjekk produktdetaljene for oppbevaring og retningslinjer for batch. Emballasjen angir tydelig at den er for tørrgjærpakker, inkluderer instruksjoner for rehydrering og oppgir Lallemands kontaktinformasjon. Dette sikrer at kjøpet er autentisk.
I USA er det viktig å søke etter anerkjente leverandører og spesialbryggerier. De tilbyr prissammenligninger, fraktinformasjon og lageroppdateringer. Tydelige produktsider forenkler sammenligningen, hjelper til med å velge det beste stedet å kjøpe Diamond-lagergjær og bekrefter tilgjengelighet.

Forstå anbefalte gjæringstemperaturer
Lallemand LalBrew Diamond trives under jevne forhold. De fleste bryggere sikter mot en Diamond-gjæringstemperatur på rundt 10°C. Konsensus er at lagergjæring bør foregå mellom 10–19°C for en ren og frisk smak.
Mange hjemmebryggere oppnår suksess ved å gjære mellom 20 °C og 15 °C. De bruker ofte en kjølig kjeller eller en fryseboks med en kontroller for å opprettholde denne temperaturen. Denne tilnærmingen bidrar til å bevare de delikate smakene av malt og humle, samtidig som den minimerer fruktige estere.
I løpet av de første 24 timene kan man forvente lav aktivitet rundt 10 °C. Innen 48 timer blir bobler og krausen mer synlige. Diamantgjæring er kjent for å starte sakte, men deretter få fart jevnt og trutt, uten voldsom skumming.
Konsekvent temperaturkontroll er nøkkelen til å unngå uønskede estere eller svoveltoner. Det er viktig å opprettholde en jevn lagergjæringstemperatur på 10–16 °C. Dette bidrar til å holde diacetylproduksjonen lav og støtter ren fortynning.
Erfarne bryggere anbefaler å stille inn fryseboksens kontrollere en grad eller to lavere enn måltemperaturen. Dette kompenserer for varmen som genereres av aktiv gjæring. Det er viktig å overvåke temperaturene med en sonde. Små, jevne justeringer er bedre enn store svingninger for å oppnå den klassiske lagerkarakteren.
Pitchingtemperatur og beste praksis
Det krever nøye tilsetning av tørrgjær i vørteren. De fleste bryggere anbefaler tilsetning ved gjæringstemperatur eller litt lavere. For LalBrew Diamond er det ideelt å sikte på 10–14 °C når man gjærer mellom 15–16 °C.
Mange bryggere foretrekker å brygge ølet rundt 10–12 °C, og unngår å starte ved varmere øltemperaturer. Å starte varmt og deretter avkjøle det kan stresse gjæren. Dette stresset øker risikoen for bismak og lengre ventetider.
Det er viktig å følge beste praksis for gjærpitching. Dette inkluderer skånsom lufting, rent utstyr og presise pitching-hastigheter. Tørre sorter kan pitches direkte uten rehydrering, men følg Lallemands råd om dette.
Noen bryggere varmer opp gjæringstanken etter påfylling for å fremskynde gjæringen. Denne metoden bør brukes sparsomt. Mange prioriterer ølkvalitet fremfor rask gjæringsstart.
- Måltemperatur for gjæring for Diamond: 10–14 °C ved gjæring på omtrent 15–16 °C.
- Hakk ved gjæringstemperatur eller litt kaldere; unngå å hakk veldig varmt og kjøle det ned senere.
- Forvent minimal tidlig luftsluseaktivitet; ikke bedøm gjæringen utelukkende ut fra bobling.
Å følge beste praksis for gjærpitching minimerer stress og forbedrer demping. Riktig temperaturkontroll i begynnelsen er nøkkelen til å oppnå en ren og balansert lagerøl.

Veiledning for start- og pitchhastighet for LalBrew Diamond
For en første lagerøl i et batch på over 20 liter, følger mange hjemmebryggere en anbefaling om to pakker. Dette sikrer kraftig gjæring. LalBrew Diamond foreslår moderat overgjæring for å unngå undergjæring, noe som er kritisk for sterkere originale vekter.
Tørrgjær er robust, men en gjærstarter for tørrgjær kan være gunstig. Det er nyttig når tyngdekraften er høy eller når du planlegger å sette i gang en ny gjærblanding. Å lage en starter fra en rehydrert tørrgjærblanding øker celletallet og forkorter forsinkelsesfasen. Dette reduserer sjansen for bismak.
- Bruk to pakker for standard øl på 5–6 gallon som et grunnlag.
- Øk tonehøyden for vørter med høyere gravitasjon eller større volumer.
- Hvis du velger én pakke, planlegg en gjærstarter for tørrgjær for å øke levedyktigheten.
Kortere forsinkelsesfase forbedrer gjæringshelsen og smaken. En korrekt LalBrew Diamond-gjæringsmengde reduserer diacetyl og estere ved å få gjæren aktiv raskere. Bryggere som ønsker å unngå undergjæring, synes ofte at to-pakkemetoden er enkel og pålitelig.
Når du er i tvil, mål tyngdekraften og beregn cellemengden, eller velg anbefalingen om to pakker. Dette lille trinnet holder gjæringen ren og forutsigbar. Det beskytter ølet ditt mot vanlige gjæringsfeil.
Fermenteringshåndtering: Fra forsinkelsesfase til diacetylhvile
LalBrew Diamond-gjær opplever vanligvis en kort forsinkelsesfase ved standard lagertemperaturer. De første 24 timene har ofte en langsom start, mer uttalt i den nedre enden av det anbefalte området. Rundt 48 timer starter aktiv gjæring vanligvis når forholdene er optimale.
Det er tilrådelig å bruke et hydrometer for å overvåke gjæringen fremfor luftsluseaktivitet. Regelmessige tyngdekraftsmålinger bekrefter sukkerforbruket, noe som eliminerer behovet for spekulasjon. Denne tilnærmingen minimerer stress knyttet til den tidlige stille fasen.
Det er viktig å implementere et diacetylrestgjærtrinn mot slutten av den primære gjæringen. En liten temperaturøkning oppmuntrer gjæren til å reabsorbere diacetyl. Hjemmebryggere hever ofte temperaturen til 16–19 °C når gjæringen nærmer seg fullført, noe som indikeres av tyngdekraftavlesninger.
Det er kritisk å bestemme tidspunktet for temperaturøkningen, basert på endringer i tyngdekraften og gjæraktiviteten. En beskjeden økning kan fremskynde oppryddingen og forbedre dempingen hvis tyngdekraften har avtatt, men ikke er ferdig. Gradvise endringer er nødvendige for å unngå å gi gjæren sjokk.
Det er viktig å dokumentere temperaturer, tyngdekraft og timing. Tydelige registreringer forenkler gjentakelsen av vellykkede brygg med Diamond-gjær. Tålmodighet og grundig kontroll over temperatur og hygiene er nøkkelen til å oppnå renere lagerøl.
- Sjekk tyngdekraften, ikke boblene, for fremgang.
- Forvent 24–48 timer før synlig aktivitet øker.
- Øk temperaturen med noen grader for å rense opp diacetylrestgjær.
- Unngå å forhaste primærgjæringen; la gjæren fullføre arbeidet sitt.
Temperaturkontrollalternativer for hjemmebryggere
Effektiv temperaturkontroll er nøkkelen til å brygge en ren lagerøl. For mange er gjæring i en kjølig kjeller nær 10–15 °C den enkleste metoden. Denne tilnærmingen eliminerer behovet for elektronikk og sikrer at gjæren oppfører seg forutsigbart.
Uten tilgang til kjeller er det et godt alternativ å bruke en fryseboks med en dedikert temperaturkontroller. Kontrollere som Inkbird eller Johnson Controls tilbyr presis temperaturkontroll. Dette oppsettet muliggjør programmering av en diacetylhvile, noe som gir nøyaktige resultater uten en høy startinvestering.
For de med et begrenset budsjett finnes det alternativer som et lite kjøleskap med en ekstern kontroller eller å plassere gjæringstanken i et kar med kaldt vann. Ispakker kan byttes ut for raske temperaturjusteringer. Noen bryggere bruker en glykolkjøler for raske temperaturfall, og lar deretter kontrolleren justere seg til måltemperaturen.
- Kjellerlagring: minimal kostnad, best for naturlig kjølige hjem.
- Fermentering i fryser: presis kontroll, vanlig valg for hobbyister.
- Vannbad og isposer: raske, midlertidige justeringer som fungerer i en knipe.
Konsistens er viktigere enn å oppnå perfekte temperaturer. Små temperaturtopper, som å åpne en fryserdør, kan øke luftsluseaktiviteten. Disse små svingningene skader sjelden et parti, så lenge det generelle temperaturområdet holder seg innenfor akseptable grenser.
Overvåking og innstilling av alarmer er viktig. Detaljerte logger bidrar til å identifisere trender og forbedre temperaturkontrollteknikkene dine. Selv små investeringer kan føre til renere og mer konsistente lagerøl over tid.
Dempning, smaksutfall og feilsøking
LalBrew Diamond er kjent for sin rene demping, perfekt for bleke lagerøl. Den gir en fast ettersmak, selv med enkle maltnøtter. For en sprø lagerøl kan du forvente god klarhet etter skikkelig kondisjonering og kaldlagring.
Vanlige lagersmaker inkluderer en nøytral, avrundet maltryggrad med lav estertilstedeværelse. Riktig gjæring og kondisjonering resulterer i lyse maltnoter og minimale bismaker. Et lett brunt gjærlag på vørteren før aktiv bobling er vanligvis en gjær som har bunnfestet seg, ikke en feil.
Hvis gjæringen er treg etter 48 timer, start feilsøking av Diamond-gjær. Sjekk gjærhastigheten, temperaturen og sanitærforholdene. Treg start er normalt ved lavere lagertemperaturer. Bekreft tyngdekraftavlesningene før du gjør betydelige endringer. Å øke temperaturen noen grader kan stimulere gjæren uten å skade den endelige profilen.
Vurder langsomme gjæringsløsninger, som å lage en starter eller bruke to pakker på tidlige batcher hvis det er mistanke om undergjæring. Mål spesifikk vekt over tid for å bekrefte fremdriften. Hvis tyngdekraften stopper, vurder oksygeninnhold og næringsnivåer før du gjærer på nytt eller varmer opp gjæringstanken.
- Se etter jevne tyngdekraftsfall, ikke bare overflateaktivitet.
- Juster tonehøydehastigheten eller legg til en starter for øl med høy vekt eller for lav tonehøyde.
- Bruk kontrollerte temperaturøkninger for å gjenopplive treg gjæring.
Å holde god oversikt over originale og nåværende gravitasjonsavlesninger hjelper med å diagnostisere problemer og bekrefte Diamond-dempningen for fremtidige brygg. Riktig pitching, temperaturkontroll og tålmodighet er nøkkelen når man feilsøker Diamond-gjær og oppnår ønskede lagersmakresultater.
Avklaring, bøter og lagringspraksis
Etter primærgjæringen, la ølet hvile i en kort kondisjoneringsperiode. Utfør en diacetylhvile nær 15–19 °C i 24–48 timer for å hjelpe LalBrew Diamond med å ferdigstille smøraktige forløpere. Begynn deretter å gå over til kaldkondisjonering av Diamond-gjæren ved å gradvis senke temperaturen til lagertemperaturer.
De fleste hjemmebryggere lager øl etter et par uker, men mange rapporterer at lengre lageringsperioder gir bedre resultater. Sikt på 3–4 uker ved temperaturer rundt 1–2 °C for å la smakene modnes og sterke estere mykne. Tålmodighet forbedrer munnfølelsen og den langsiktige stabiliteten.
Bruk kaldkrasjteknikker for å fremskynde sedimenteringen før overføring. Avkjøl gjæringstanken til rett over frysepunktet i 24–72 timer for å fremme klaring av ølet. Dette trinnet reduserer gjær- og proteindis, noe som gjør fining av øl nedstrøms mer effektiv.
Vanlige klaringsmidler inkluderer gelatin og irsk mose. Tilsett gelatin etter kaldpressing for rask klaring. Vær oppmerksom på dosering og tidspunkt for å unngå å fjerne den delikate humlekarakteren i lettere lagerøl.
For naturlig klarhet, la tyngdekraften og tiden gjøre jobben. Forsiktig pressing fra trubben minimerer gjenavleiring av faste stoffer. Hvis ølet serveres for tidlig, kaller smakerne det ofte «litt grønt». Forlenget kaldkondisjonering med diamantgjær korrigerer dette ved å runde av smakene og forbedre klarheten.
Vurder sekundær kondisjonering i en tønne eller blank tank for endelig polering. Hold lagringstemperaturen stabil og unngå omrøring slik at suspenderte partikler kan legge seg. Disse kombinerte lagringspraksisene og riktige fineringstrinnene for lagerøl gir den rene, sprø profilen som forventes av klassiske lagerøl.

Omprøving og høsting av LalBrew Diamond Yeast
Hjemmebryggere diskuterer ofte om de skal bruke LalBrew Diamond-gjær på nytt eller høste tørrgjær til fremtidige brygg. LalBrew Diamond markedsføres som tørrgjær for engangsbruk. Denne tilnærmingen sikrer jevn fortykning og ren lagerkarakter.
Noen bryggere foretrekker å høste slam fra gjæringstanker for gjenbruk, en vanlig praksis med flytende kulturer. Denne metoden kan spare penger og fremskynde bryggeplanene. Likevel medfører den risikoer. Høstet gjær må være synlig sunn, håndteres med streng hygiene og lagres kaldt for å opprettholde vitaliteten.
Rapporter fra lokalsamfunnet viser blandede resultater fra forsøk på å ompiske LalBrew-kulturer. Noen få bryggerier har lykkes med å bære kulturer i generasjoner med omhyggelig forsiktighet. Ytelsen avtar vanligvis etter flere generasjoner, noe som fører til tregere starter eller bismak.
- Sjekk levedyktighet: bruk et mikroskop eller en enkel levedyktighetstest før gjenbruk.
- Begrens generasjoner: unngå mer enn to til tre repetisjoner for å redusere drift.
- Desinfiser grundig: forurensning er den største faren når du høster tørrgjær.
Mange hjemmebryggere velger ferske pakker for hver batch for å sikre pålitelige resultater. Denne metoden eliminerer usikkerhet og støtter konsistente gjæringstidslinjer for lagerøl.
Hvis du bestemmer deg for å høste, bør du utvikle en plan for gjærhåndtering. Vurder batchets tyngdekraft, gjæringstemperatur og bryggefrekvens. Hold oversikt over bryggehistorikken og se etter tegn på stress. Dette vil hjelpe deg å vite når du skal bytte tilbake til ferske LalBrew Diamond-pakker.
Hjemmebryggingsopplevelser og tips fra den virkelige verden
Hjemmebryggere deler praktiske tips om bruk av diamantgjær. Førstegangsbrukere gjærer ofte ved 15 °C i kjellere eller kjølige rom. Noen bruker to pakker for å unngå for lite gjær, da startergjær kan være upraktisk.
Erfarne bryggere legger merke til moderat luftsluseaktivitet de første dagene. De beskriver en klassisk lagerduft med lette svovelaktige toner etter hvert som gjæringen intensiveres. Denne lukten avtar vanligvis når aktiviteten topper seg og gjæren setter seg.
Praktiske tips for lagerbrygging inkluderer mesketemperaturer på 60–74 °C for balansert fylde og ren avslutning. Bryggere legger vekt på tålmodighet og bruk av et hydrometer for tyngdekraftssjekker, slik at de unngår å være avhengige av luftsluser.
Praktiske feilsøkingstips legger vekt på å sette gjæringen på eller nær måltemperaturen for gjæring. Hvis gjæringen virker treg, øk temperaturen mot den øvre enden av det anbefalte området. Unngå å sette den på nytt umiddelbart.
- Forvent beskjeden krausen og en jevn, ikke voldsom, gjæring.
- Prioriter en riktig pitchrate; to pakker kan redusere risikoen for større partier.
- Bruk hydrometeravlesninger for å bekrefte fremgangen før du iverksetter korrigerende tiltak.
Andre anekdoter om feilsøking advarer mot snarveier som går på bekostning av smaken. Bryggere oppnår bedre klarhet og færre bismaker ved å tilpasse tonehøyde og gjæringstemperaturer nøye.
Kollektive erfaringer viser at små justeringer – som å justere diacetylhviletiden og langsom avkjøling under lagring – gir renere lagerøl. Disse tipsene gjenspeiler praktiske forsøk fra hobbybryggerier og småskalabryggerier.
Lallemand LalBrew Diamond Lager-gjær
LalBrew Diamond er en tørr lagergjær fra Lallemand, perfekt for hjemmebryggere som sikter mot rene og pålitelige gjæringer. Denne konsise anmeldelsen fremhever dens jevne dempning, lave esterproduksjon og sterke flokkulering. Disse egenskapene bidrar til at ølet blir klart etter lagring.
Emballasjen til LalBrew Diamond er allment tilgjengelig i USA gjennom hjemmebryggerier og nettforhandlere. Den kjøpes vanligvis i enkeltpakker eller flerpakninger. Mange amerikanske hjemmebryggere starter med to pakker for fem-gallons batcher for å sikre en sunn bryggetempning.
Ytelsen ved lave temperaturer er en viktig styrke. LalBrew Diamond håndterer kjellergjæring nær 15 °C med forutsigbare resultater. For jevn demping og minimale bismak anbefales aktiv temperaturkontroll. Dette kan inkludere bruk av kjøleskap eller fryser med en kontroller for amerikanske hjemmebryggergjæroppsett.
- Forutsigbar ren profil som passer til pilsner og klassiske lagerøl
- God klarhet etter skikkelig lagring og kaldbehandling
- Enkel oppbevaring og dosering sammenlignet med flytende stammer
Erfarne bryggere i USA tilbyr praktiske tips. De foreslår å varme opp gjæren litt før tilsetning, og vurderer en startergjær eller dobbel gjæring på oppskrifter med høy vekt. Denne anmeldelsen gjenspeiler tilbakemeldinger fra mange hjemmebryggere som verdsetter dens enkelhet og pålitelighet i hjemmemiljøer.
Sammendraget av Diamond-lagerølet fremhever balansen mellom brukervennlighet og profesjonelle resultater. Det er et sterkt alternativ for de som går over fra ekstrakt til helkornslagerøl, eller alle som ønsker jevn og ren gjæring hjemme.
Konklusjon
LalBrew Diamond sikrer rene, sprø lagerøl med enkel håndtering. Viktige punkter inkluderer å helle gjæren på eller litt under målgjæringstemperaturen din, vanligvis 10–15 °C. For førstegangsbatcher på 20 liter eller mer, bruk to pakker for å unngå undergjæring. I stedet for luftbobler, bruk tyngdekraftavlesninger for nøyaktig gjæringssporing.
Hold deg til en tidsplan: en aktiv gjæringsfase, en diacetyl-hvil og kald lagring for å forbedre smak og klarhet. Å opprettholde jevne temperaturer, enten i en kjølig kjeller eller en fryser med en kontroller, minimerer bismak. Denne tilnærmingen hjelper Diamond med å oppnå sin rene profil. Disse trinnene er viktige for Diamond-gjærbrukere å følge.
Kort sagt er LalBrew Diamond et pålitelig valg for amerikanske hjemmebryggere som sikter mot tradisjonelle lagersmaker. Med riktig pitching, temperaturkontroll og tålmodighet under lageringen kan hjemmebryggere konsekvent produsere klassiske, lyse lagerøl.
Videre lesing
Hvis du likte dette innlegget, kan du også like disse forslagene:
- Gjæring av øl med Lallemand LalBrew Abbaye-gjær
- Gjæring av øl med Fermentis SafLager S-23 gjær
- Gjæring av øl med Wyeast 2308 München Lager-gjær
